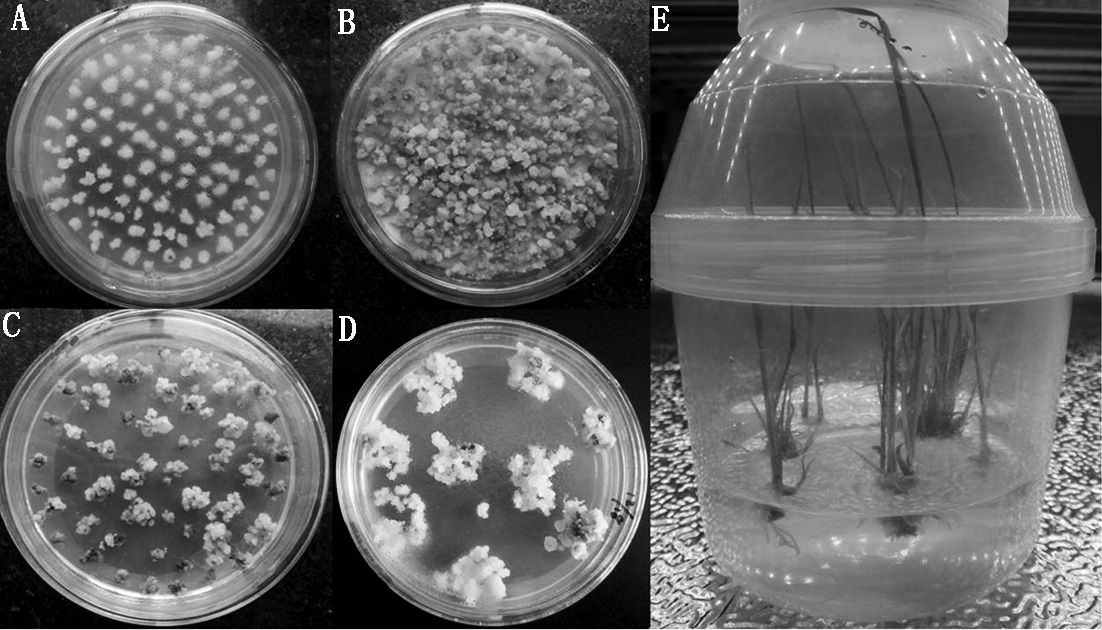

摘要:为了挖掘水稻苗期耐冷基因,基于比较转录组分析,参考公共数据库中的基因序列信息设计靶位点,对冷胁迫条件下东乡野生稻苗期下调表达耐冷相关基因BGIOSGA032296 进行TALEN基因组编辑技术构建,克隆酶切鉴定和序列比对结果表明, BGIOSGA032296 TALEN敲除植物表达载体1301TALEN-032296构建成功,利用农杆菌介导法将TALEN敲除植物表达载体1301TALEN-032296转入水稻受体品种TP309,获得了17株转基因水稻植株,经潮霉素抗性标记基因和Fok I基因特异引物PCR检测,表明获得的转基因植株皆为携带1301TALEN-032296的阳性植株。该研究为水稻BGIOSGA032296基因后续耐冷表型鉴定奠定了前期基础。
关键词:比较转录组;东乡野生稻;TALEN基因组编辑技术
水稻发源于热带和亚热带气候地区,对低温冷害特别敏感,在我国不同的水稻种植区,水稻的生长发育阶段经常会受到低温冷害的不利影响,低温冷害已经成为制约水稻产量和种植面积最主要的环境因素,转基因技术被认为是改善水稻耐冷性的重要途径,然而,对于转基因策略而言,一个重要的前提是要克隆和鉴定出大量能够提高水稻耐冷性的耐冷基因。
基因的过表达分析和基因沉默(RNAi)是目前进行未知基因功能鉴定的2种最主要的方法,通过构建基因的过表达载体已经从水稻中鉴定了OsMYB3R-2[1]、Osmyb4[2]、OsTPS1[3]、microRNA319[4]和OsDREB1F[5]等一些水稻耐冷基因,而传统的基因沉默(RNAi)技术由于存在脱靶效应以及对基因的表达干扰不彻底等缺陷,在很大程度上限制了其在基因功能鉴定方面的应用,因此,迫切需要具有更高专化性和更低脱靶频率的新基因组编辑技术来弥补这一不足,TALENs(Transcription activator-like(TAL)effector nu-cleases)基因组编辑技术正好迎合人们的这一期望,TALENs 基因组编辑技术是近年来发展的一种崭新的靶向基因敲除技术,该技术2012年12月被 Science 杂志评为年度十大科学进展之一[6],TALENs技术的设计和构建是基于植物病原体黄单胞菌(Xanthomonas)分泌的一种转录激活效应因子对DNA序列能够进行特异性识别的原理[7-9]。TALEN蛋白的核酸结合域的氨基酸序列与其结合的靶位点的核苷酸序列有恒定的对应关系,由34个氨基酸重复序列组成一个单元,识别一个特定的核苷酸[10-11],因此,利用TAL的序列模块可以组装成能够特异结合任意DNA序列的模块蛋白。TALEN是由TALEN蛋白的DNA结合结构域与Fok Ⅰ内切酶的切割结构域连接而成的嵌合酶,能够在DNA链特定位点造成双链断裂(DSB)[12],而DSB能够激活细胞内固有的非同源末端连接(Non-homologous end joining,NHEJ)或同源重组(Homologous recombination,HR)机制,对损伤的DNA进行修复[13-15]。其中NHEJ 是一种相对较为简单的修复方式,保真度不高,很容易造成DNA断裂处修复之后的序列发生改变,导致DNA的小片段插入或缺失(Indel),从而造成基因突变。TALENs基因组编辑技术因不受任何基因序列、细胞以及物种的限制,且试验操作相对简单、成本消耗低,近年来,TALENs靶向基因敲除技术已被广泛应用于动物(人类、家畜、鼠、斑马鱼、爪蟾、家蚕)[16-21]、植物(烟草、水稻、短柄草、拟南芥)[9,22-23] 以及微生物(酵母、病毒)[13,24]等的功能基因研究。并取得了一定的成效。
基于前期比较转录组分析结果[25],本研究利用TALENs基因组编辑技术,对在冷敏感水稻93-11中冷处理前后无差异表达,而在耐冷东乡野生稻中表达量显著下调的耐冷相关基因BGIOSGA032296于同样具有较强耐冷性的水稻受体品种TP309中实施TALEN靶向基因敲除,旨在为水稻苗期耐冷相关基因BGIOSGA032296后续的突变体植株筛选及其耐冷表型鉴定奠定基础。
1.1 试验材料
1.1.1 植物材料 水稻转基因受体材料为粳稻(Oryza sativa L.japonica)品种TP309,以其幼胚作为外植体。
1.1.2 载体与菌株 TALEN左右臂骨架载体(L20和R16)(图1,2)、植物双元表达载体1301-nos由上海斯丹塞公司提供,大肠杆菌感受态细胞Trans5α购自全式金生物公司,农杆菌菌株EHA105由江西省作物生长发育调控实验室保存。

图1 TALEN左臂骨架载体L20示意图
Fig.1 The map of TALEN left arm vector L20

图2 TALEN 右臂骨架载体R16示意图
Fig.2 The map of TALEN right arm vector R16
1.1.3 主要试剂 植物TALEN试剂盒购自上海斯丹塞公司(溶液1、溶液2、溶液3、溶液4、溶液5、TALEN模块、SOC、感受态细胞、TALEN左右臂骨架载体L20和R16);KOD高保真DNA聚合酶购自TOYOBO公司;分子量标记DL15000、DL2000购自TaKaRa公司;限制性内切酶购自Fermentas公司;T4 DNA连接酶、质粒提取试剂盒Easypure®Hipure Plasmid Miniprep Kit,购自全式金生物公司;引物由深圳华大基因技术有限公司合成;其余组织培养试剂均为国产分析纯产品。
1.2 试验方法
1.2.1 TALEN左、右臂识别序列设计 按照上海斯丹塞公司的植物TALEN试剂盒说明中的TALENs设计原则,在BGIOSGA032296的第2个外显子内设计1对TALEN左、右臂识别序列(表1)。
1.2.2 TALEN模块与左、右臂骨架载体分别连接 将左、右臂识别序列的最后一位碱基T去除,以1个或2个碱基组合为1个模块,把首个碱基标记为1,最后一个碱基标记为9,依次类推进行标记。按标记方式于试剂盒的模块中选择相对应编号的模块,具体操作按上海斯丹塞TALEN试剂盒使用说明书进行。
表1 BGIOSGA032296 TALEN左、右臂设计
Tab.1 Design of left and right arm TALEN for BGIOSGA032296

名称Name正链或负链Positivechain/Negativechain序列(5'-3')Sequence位置(基因中)Position长度/bpLength左臂Leftarm正链 CGACCAACTTCCCT2287-230014右臂Rightarm负链 GTGTGTTTCCTT-GAT2315-232915间隔Spacer16
1.2.3 TALEN敲除表达载体转化水稻受体品种 使用电穿孔法将过敲除载体导入根癌农杆菌EHA105感受态细胞中,借助农杆菌介导转化水稻受体品种TP309,培养基配方及具体操作参照李丁[26]的方法进行。
1.2.4 引物设计 参照载体上潮霉素基因和Fok Ⅰ基因序列,利用软件Primer Premier 5.0设计特异引物,序列见表2。
表2 转基因植株PCR阳性鉴定引物
Tab.2 PCR primer for positive identificationof the transgenic plants

引物名称Primername序列(5'-3')Sequence片段长度/bpFragmentlengthHpt-FGCTTCTGCGGGCGATTTGTG929Hpt-RCTGAACTCAC-CGCGACGTCTGFok-FGCTGAACCACATCAC-CAACTG2563Fok-RCGCCATTGCAGTTGGTTT
2.1 低温诱导条件下BGIOSGA032296基因的表达
基于冷敏感水稻品种93-11和耐冷东乡野生稻在冷处理条件下(4 ℃处理3 d)的转录组比较分析结果,本研究获得了冷处理前后在冷敏感水稻93-11无表达差异(∣log2Ratio∣≥1符合差异表达),而在东乡野生稻中表达量下调倍数较高的基因BGIOSGA032296(表3),为了验证转录组测序结果,分别从93-11和耐冷东乡野生稻幼苗叶片提取总RNA,取4 μg总RNA进行反转录,以水稻Actin肌动蛋白基因为内标,利用半定量RT-PCR方法对BGIOSGA032296在冷胁迫条件下(4 ℃处理3 d)的表达进行了分析,结果显示试验结果与测序分析结果一致(图3),BGIOSGA032296在冷敏感水稻93-11冷处理前后表达丰度相当,而在耐冷东乡野生稻中冷处理后表达丰度下调。
表3 冷处理前后BGIOSGA032296在93-11和东乡野生稻中的表达情况
Tab.3 Expression of BGIOSGA032296 in Dongxiang wild rice and 93-11 before and after cold treatments.

水稻品种Ricevariety读段1Read1读段2Read2RPKM1RPKM2log2Ratio上调/下调Up/Down东乡野生稻Dongxiangwildrice80213.960.42-5.06下调93-11450.670.980.54上调
注:读段1、读段2.冷处理前、后在BGIOSGA032296 位点表达谱测序检测到的读段数目;RPKM1、RPKM2.冷处理前、后的表达量;Ratio.同一基因处理组与对照组的RPKM 的比值。
Note:Read 1 and Read 2 are the read number of BGIOSGA032296 detected in RNA-seq before and after cold treatment;RPKM1 and RPKM2 are the expression before and after cold treatment;Ratio.Ratio of RPKM of exposure group compared with RPKM of control group.

9311-1.冷处理前在93-11中的表达量;9311-2.冷处理后在93-11中的表达量;DX-1.冷处理前在东乡野生稻中的表达量;DX-2.冷处理后在东乡野生稻中的表达量。9311-1.Expression in 93-11 before cold treatment;9311-2.Expression in 93-11 after cold treatment;DX-1.Expression in Dongxiang wild rice before cold treatment;DX-2.Expression in Dongxiang wild rice after cold treatment.
图3 冷处理前后BGIOSGA032296的表达模式
Fig.3 Expression of BGIOSGA032296 gene before and after cold treatments
2.2 BGIOSGA032296敲除靶位点左、右臂TALEN载体构建
2.2.1 重组左、右臂质粒载体酶切鉴定 将左臂识别序列5′-CGACCAACTTCCCT-3′的3′端去除最后一个T,其余碱基标记为C1、G2、A3、C4、C5、AA6、CT7、TC8、CC9,根据选择的标记方式在试剂盒的模块中选择对应编号的模块与试剂盒中已处理好的线性左臂TALEN骨架载体L20进行9个片段的同时连接(TALEN蛋白模块插入位点为L20的BamHⅠ和Spe Ⅰ的2个酶切位点之间),热激转化后挑取单克隆菌落,重组左臂质粒载体使用BamH Ⅰ和Spe Ⅰ进行双酶切鉴定,左臂TALEN识别序列为13个碱基,酶切之后正确的阳性克隆应出现2条带,分别为4 850 bp(5 670-820)和2 146 bp(102×13+820)(102 bp为每个碱基对应的TALEN蛋白模块大小,820 bp为同时酶切下来的左臂TALEN骨架载体中BamH Ⅰ和Spe Ⅰ位点之间的序列),双酶切结果显示已鉴定到片段大小正确的重组左臂TALEN载体L20-032296(图4)。右臂识别序列5′-GTGTGTTTCCTTGAT-3′,将3′端最后一个T去除,其余碱基标记为G1、T2、G3、T4、GT5、TT6、CC7、TT8、GA9,根据选择的标记方式在试剂盒的模块中选择对应编号的模块与试剂盒中已处理好的线性右臂TALEN骨架载体R16进行9个片段的同时连接(TALEN蛋白模块插入位点为R16的BamH Ⅰ和PstⅠ的2个酶切位点之间),然后热激转化大肠杆菌,挑取单克隆菌落,重组右臂质粒载体使用BamH Ⅰ和Pst Ⅰ进行双酶切鉴定,右臂TALEN中连接的识别序列为14个碱基,则酶切后正确的阳性克隆应该出现2条带分别为3 782 bp(4 313-531)和1 959 bp(102×14+531)(531 bp为同时酶切下来的右臂TALEN骨架载体中BamH Ⅰ和Pst Ⅰ位点之间的一段序列),重组质粒酶切后电泳结果显示已鉴定到片段大小正确的重组右臂TALEN载体R16-032296(图4)。
2.2.2 左臂TALEN重组克隆测序及序列比对 将酶切鉴定结果正确的重组质粒送测序,并与设计的标准序列进行比对,根据每个碱基对应的TALEN蛋
白模块包含102个核苷酸序列(34个氨基酸),左臂TALEN模块拼接后对应的标准核苷酸序列总长为102×13=1 326 bp,在NCBI中选择tBlastX,将拼接好的标准核苷酸序列与测序序列输入到对应的框中,正向测序序列(Sbjct)与标准序列(Query)的比对(氨基酸比对)结果表明,左臂TALEN模块的1-729 bp为100%正确(图5),反向测序序列(Sbjct)与标准序列(Query)的比对结果表明左臂TALEN模块的388-1 326 bp区段为100%正确(图6)。因此,本研究成功构建了正确的左臂TALEN载体。得到了正确的重组质粒L20-032296。

M.DNA Ladder;1.重组左臂TALEN L20-032296的BamH Ⅰ和Spe Ⅰ酶切鉴定;2.重组右臂TALEN R16-032296的BamH Ⅰ和Pst Ⅰ酶切鉴定。
M.DNA Ladder;1.Double digestion of recombinant left arm TALEN by BamH Ⅰ and Spe Ⅰ;2.Double digestion of recombinant right arm TALEN by BamH Ⅰ and Pst Ⅰ.
图4 L20-032296和R16-032296酶切鉴定
Fig.4 Digestion identification of L20-032296 and R16-032296

图5 重组质粒L20-032296正向测序序列与标准氨基酸序列的比对
Fig.5 Alignment of standard amino acid sequence and forward sequencing results of L20-032296 plasmid

图6 重组质粒L20-032296反向测序序列与标准氨基酸序列的比对
Fig.6 Alignment of standard amino acid sequence and reverse sequencing results of L20-032296 plasmid
2.2.3 右臂TALEN重组克隆测序及序列比对 同样,对右臂识别序列所对应的TALEN蛋白模块的核苷酸序列进行拼接,右臂TALEN模块拼接后总长为102×14=1 428 bp,正向测序序列(Sbjct)与标准序列(Query)的比对结果表明右臂TALEN模块的1-600 bp为100%正确(图7),反向测序反应序列(Sbjct)与标准序列(Query)的比对结果表明右臂TALEN模块的487-1 428 bp区段为100%正确(图8)。表明右臂TALEN载体构建成功,得到了正确的重组质粒R16-032296。

图7 重组质粒R16-032296正向测序序列与标准氨基酸序列的比对
Fig.7 Alignment of standard amino acid sequence and forward sequencing results of R16-032296 plasmid

图8 重组质粒R16-032296反向测序序列与标准氨基酸序列的比对
Fig.8 Alignment of standard amino acid sequence and reverse sequencing results of R16-032296 plasmid
2.3 BGIOSGA032296 TALEN敲除植物表达载体构建
TALEN敲除植物表达载体构建流程如图9所示,将测序正确的重组左臂载体(L20重组质粒)用Hind Ⅲ和Asc Ⅰ进行酶切,然后电泳回收含有TALEN序列的约5 kb大片段(即3 725 bp+TALEN左臂识别模块序列)。同时,使用Sac Ⅰ和Asc Ⅰ双酶切,从构建正确的重组右臂载体(R16重组质粒)切下含有TALEN序列的约4 kb的大片段(即2 238 bp+TALEN右臂识别模块序列),回收。将胶回收得到的TALEN左、右臂DNA片段与经Hind Ⅲ和Sac Ⅰ双酶切后约8 kb的植物表达载体1301-nos的大片段进行三片断连接,转化大肠杆菌感受态细胞后挑取单菌落,使用Hind Ⅲ和Sac Ⅰ进行双酶切验证,酶切电泳后显示出现了8,5,4 kb的3个条带,表明BGIOSGA032296的TALEN敲除植物表达载体1301TALEN-032296已经构建成功(图10),质粒测序结果也证实TALEN植物表达载体构建正确。
2.4 遗传转化及转基因植株的PCR阳性检测
将TALEN敲除植物表达载体1301TALEN-032296的农杆菌克隆侵染受体水稻品种TP309的胚性愈伤组织,经共培养后、将愈伤组织接入到50 mg/L潮霉素筛选培养基上,进行3~4次筛选获得抗性愈伤(15 d更换一次筛选培养基)、经分化培养和生根培养等试验过程,TALEN敲除植物表达载体1301TALEN-032296共获得17株独立转基因植株,水稻遗传转化过程如图11所示。潮霉素抗性标记基因和Fok Ⅰ基因特异引物分子检测结果表明,2对引物在所有转基因植株中都扩增出了相应的目的条带,而阴性对照中没有扩增出对应条带,说明17株转基因植株都为阳性,图12,13为部分转基因植株的检测结果。
Agarwal等[27]发现MYB15转录因子通过与ICE1基因相互作用负调控水稻耐冷基因CBF2的表达;Vogel等[28]研究表明锌指蛋白类转录因子ZAT12同样负调控CBF2基因的表达;Liu等[29]研究也证实水稻耐冷基因OsbZIP52作为一个负调控因子在冷胁迫条件下起作用。可见,除了正调控,水稻在冷胁迫过程中可能通过一些基因的下调表达(负调控)增强自身的耐冷性,在本研究中,基于转录组测序和半定量分析证实BGIOSGA032296冷处理前后在冷敏感水稻93-11中无差异表达,而在耐冷东乡野生稻中表达量下调较高,笔者推测在冷胁迫条件下,该基因可能通过负调控增强东乡野生稻的耐冷性。因此,本研究通过对BGIOSGA032296于同样具有较强耐冷性的粳稻品种台北309中实施TALEN靶向基因敲除,以期为后续的靶基因突变体耐冷表型鉴定奠定基础。

图9 植物表达载体1301TALEN的构建流程图
Fig.9 Construction of plant expression vector 1301TALEN

M.DNA Ladder;1.假阳性 2.重组质粒
1301TALEN-032296的Hind Ⅲ和Sac Ⅰ酶切鉴定。
M.DNA Ladder;1.False positive;2.Double digestion of 1301TALEN-032296 plasmid by Hind Ⅲ和Sac Ⅰ.
图10 重组质粒1301TALEN-032296的酶切鉴定
Fig.10 Digestion identification of 1301TALEN-032296
A.愈伤组织预培养;B.愈伤组织与农杆菌的共培养;C.筛选培养基上长出的抗性愈伤组织;D.抗性愈伤组织的再分化;E.转化植株的生根壮苗。A.Callus preculture;B.Coculture of calli with agrobacterium;C.The resistant callus;D.Resistant calli redifferentiation;E.Rooting of transgenic seedling.
图11 水稻遗传转化过程实物图
Fig.11 The map of rice genetic transformation process

M.DNA Ladder;1.野生型阴性对照;2.1301TALEN-032296质粒阳性对照;3~17.转基因植株。
M.DNA Ladder;1.Wild type negative controls;2.1301TALEN-032296 plasmid positive control;3-17.Transgenic rice plants.
图12 1301TALEN-032296转基因植株潮霉素引物PCR阳性鉴定
Fig.12 PCR identification of transgenic rice lines of 1301TALEN-032296 with hygromycin primer

M.DNA Ladder;1.野生型阴性对照;2.1301TALEN-032296质粒阳性对照;3~17.转基因植株。
M.DNA Ladder;1.Wild type negative controls;2.1301TALEN-032296 plasmid positive control;3-17.Transgenic rice plants.
图13 1301TALEN-032296转基因植株
Fok Ⅰ基因引物PCR阳性鉴定
Fig.13 PCR identification of transgenic rice lines of 1301TALEN-032296 with Fok Ⅰ primer
据蛋白功能注释(http://rise2.genomics.org.cn),BGIOSGA032296编码一种单加氧酶类化合物,单加氧酶能够催化有机分子直接加氧,催化反应时一个氧原子生成底物,另外一个氧原子则被还原成水,据报道,植物P450单加氧酶的生物学功能具有双重效应,一方面起解毒作用,即P450单加氧酶参与物质代谢过程中可以将杀虫剂、除草剂等有毒化合物质转化为无毒害化合物,另一方面起毒性活化作用,即为了抵御外界的侵害而将植物体内自身无毒害化合物转化为有毒化合物[30],这一特性使得单加氧酶在植物的次生代谢方面具有非常广泛且复杂的功能。目前,有关单加氧酶在水稻冷胁迫条件下的作用仍鲜有报道,有待进一步深入研究。
本研究成功构建了BGIOSGA032296基因的一个靶位点TALEN敲除载体,然而,在BGIOSGA032296的TALEN敲除植物表达载体的转基因过程中遇到了困难,就是TALEN敲除植物表达载体的农杆菌克隆浸染愈伤组织后较难获得生长良好的抗性愈伤组织(除BGIOSGA032296之外,笔者构建的其他一些基因的TALEN敲除植物表达载体也同样存在这个问题)。由于TALEN技术是最近几年才发展起来的新技术,尤其在植物中的应用较晚,所以这一问题在过去的研究中还未见报道。目前,在植物中,TALEN敲除载体的构建,通常是把敲除靶位点的左、右臂TALEN蛋白和Fok核酸剪切酶一起构建到一个植物表达载体上,然后通过农杆菌介导导入受体细胞中,所以当TALEN敲除载体导入受体细胞后,TALEN蛋白和Fok核酸剪切酶会持续起作用对靶位点进行剪切,这样一来,只要植物细胞没来得急修复受损DNA,可能就会出现死亡,所以TALEN敲除植物表达载体在转化过程中可能会对受体细胞表现出较强“致死性”,这有可能是构建的TALEN敲除植物表达载体都较难获得生长良好的抗性愈伤组织的原因,也最终导致获得的转基因植株较少,没有检测到成功实现敲除的突变体植株;而且,由于TALEN蛋白和Fok核酸剪切酶的持续起作用,即便是靶位点在剪切受损后成功修复发生了突变,这种突变也很难稳定下来,所以,认为在TALEN植物表达载体的构建过程中,可以尝试使用诱导启动子系统,诱导启动子系统优点在于可以迅速地表达与否,特别是当外源基因可能对植物产生毒性或其他不良影响时,这一点就显得尤为重要。对于诱导启动子系统来说,只有当存在时才能启动,而去除诱导物后,基因的表达很快可以被关闭,这样就可以实现人为地精确、快速控制特定基因的表达,把左、右臂TALEN蛋白基因的其中一个启动子替换成诱导型启动子,在转基因过程中,可以在筛选培养基上先添加诱导启动子表达的诱导剂,待TALEN敲除植物表达载体发挥作用对靶位点实现剪切后,更换筛选培养基并将筛选培养基上诱导剂撤除,这样受损部位在修复后,由于没有了TALEN蛋白和Fok核酸剪切酶的持续起作用就可以稳定下来,而且,原先TALEN敲除植物表达载体在转化过程中对受体细胞所表现出的持续剪切容易导致细胞致死的缺陷也将得以改善。
参考文献:
[1] Dai X,Xu Y,Ma Q,et al.Overexpression of an R1R2R3 MYB gene,OsMYB3R-2,increases tolerance to freezing,drought,and salt stress in transgenic Arabidopsis[J].Plant Physiology,2007,143(4):1739-1751.
[2] Vannini C,Locatelli F,Bracale M,et al.Overexpression of the rice Osmyb4 gene increases chilling and freezing tolerance of Arabidopsis thaliana plants[J].The Plant Journal:for Cell and Molecular Biology,2004,37(1):115-127.
[3] Li H W,Zang B S,Deng X W,et al.Overexpression of the trehalose-6-phosphate synthase gene OsTPS1 enhances abiotic stress tolerance in rice[J].Planta,2011,234(5):1007-1018.
[4] Yang C,Li D,Mao D,et al.Overexpression of microRNA319 impacts leaf morphogenesis and leads to enhanced cold tolerance in rice(Oryza sativa L.)[J].Plant,Cell & Environment,2013,36(12):2207-2218.
[5] Wang Q,Guan Y,Wu Y,et al.Overexpression of a rice OsDREB1F gene increases salt,drought,and low temperature tolerance in both Arabidopsis and rice[J].Plant Molecular Biology,2008,67(6):589-602.
[6] Alberts B.The breakthroughs of 2012[J].Science,2012,338(6114):1511.
[7] Boch J,Bonas U.Xanthomonas AvrBs3 family-type Ⅲ effectors:discovery and function[J].Annual Review of Phytopathology,2010,48(48):419-436.
[8] Moscou M J,Bogdanove A J.A simple cipher governs DNA recognition by TAL effectors[J].Science,2009,326(5959):1501.
[9] Cermak T,Doyle E,Christian M,et al.Efficient design and assembly of custom TALEN and other TAL effector-based constructs for DNA targeting[J].Nucleic Acids Research,2011,39(12):e82.
[10] Joung J,Sander J.TALENs:a widely applicable technology for targeted genome editing[J].Nature Reviews Molecular Cell Biology,2013,14(1):49-55.
[11] Miller J C,Tan S,Qiao G,et al.A TALE nuclease architecture for efficient genome editing[J].Nature Biotechnology,2011,29(2):143-148.
[12] Christian M,Cermak T,Doyle E,et al.Targeting DNA double-strand breaks with TAL effector nucleases[J].Genetics,2010,186(2):757-761.
[13] Li T,Huang S,Zhao X,et al.Modularly assembled designer TAL effector nucleases for targeted gene knockout and gene replacement in eukaryotes[J].Nucleic Acids Research,2011,39(14):6315-6325.
[14] Mahfouz M M,Li L,Shamimuzzaman M,et al.De novo-engineered transcription activator-like effector(TALE)hybrid nuclease with novel DNA binding specificity creates double-strand breaks[J].Proceedings of the National Academy of Sciences of the United States of America,2011,108(6):2623-2628.
[15] Morbitzer R,Römer P,Boch J,et al.Regulation of selected genome loci using de novo-engineered transcription activator-like effector(TALE)-type transcription factors[J].Proceedings of the National Academy of Sciences of the United States of America,2010,107(50):21617-21622.
[16] Carlson D,Tan W,Lillico S,et al.Efficient TALEN-mediated gene knockout in livestock[J].Proceedings of the National Academy of Sciences of the United States of America,2012,109(43):17382-17387.
[17] Tong C,Huang G,Ashton C,et al.Rapid and cost-effective gene targeting in rat embryonic stem cells by TALENs[J].Journal of Genetics and Genomics,2012,39(6):275-280.
[18] Ding Q,Lee Y,Schaefer E,et al.A TALEN genome-editing system for generating human stem cell-based disease models[J].Cell Stem Cell,2013,12(2):238-251.
[19] Moore F,Reyon D,Sander J,et al.Improved somatic mutagenesis in zebrafish using transcription activator-like effector nucleases(TALENs)[J].PLoS One,2012,7(5):e37877.
[20] Sajwan S,Takasu Y,Tamura T,et al.Efficient disruption of endogenous bombyx gene by TAL effector nucleases[J].Insect Biochemistry and Molecular Biology,2013,43(1):17-23.
[21] Lei Y,Guo X,Liu Y,et al.Efficient targeted gene disruption in Xenopus embryos using engineered transcription activator-like effector nucleases(TALENs)[J].Proceedings of the National Academy of Sciences of the United States of America,2012,109(43):17484-17489.
[22] Shan Q,Wang Y,Chen K,et al.Rapid and efficient gene modification in rice and Brachypodium using TALENs[J].Molecular Plant,2013,6(4):1365-1368.
[23] Li T,Liu B,Spalding M H,et al.High-efficiency TALEN-based gene editing produces disease-resistant rice[J].Nature Biotechnology,2012,30(5):390-392.
[24] Krishnakumar R,Assad-Garcia N,Benders G,et al.Targeted chromosomal knockouts in Mycoplasma pneumoniae[J].Applied and Environmental Microbiology,2010,76(15):5297-5299.
[25] Shen C X,Li D,He R H,et al.Comparative transcriptome analysis of RNA-seq data for cold-tolerant and cold-sensitive rice genotypes under cold stress[J].Journal of Plant Biology,2014,57(6):337-348.
[26] 李 丁.以潮霉素为筛选标记的水稻叶绿体转化体系的建立[D].长沙:中南大学,2013.
[27] Agarwal M,Hao Y,Kapoor A,et al.A R2R3 type MYB transcription factor is involved in the cold regulation of CBF genes and in acquired freezing tolerance[J].The Journal of Biological Chemistry,2006,281(49):37636-37645.
[28] Vogel J T,Zarka D G,Van Buskirk H A,et al.Roles of the CBF2 and ZAT12 transcription factors in configuring the low temperature transcriptome of Arabidopsis[J].The Plant Journal,2005,41(2):195-211.
[29] Liu C,Wu Y,Wang X.bZIP transcription factor OsbZIP52/RISBZ5:a potential negative regulator of cold and drought stress response in rice[J].Planta,2012,235(6):1157-1169.
[30] Schuler M.The role of cytochrome P450 monooxygenases in plant-insect interactions[J].Plant Physiology,1996,112(4):1411-1419.
Construction of TALEN Genome-editing Technique for BGIOSGA032296 Related to Cold Tolerance in Rice Seedling Based on Comparative Transcriptome
Abstract:To dig cold tolerance genes at seedling stage of rice,based on the analysis of comparative transcriptome,TALEN genome-editing technique was constructed forBGIOSGA032296 which was down-regulated in Dongxiang wild rice seedling under cold stress.The analysis of enzyme identification and sequence alignment showed that TALEN knockout plant expression vector 1301TALEN-032296 was constructed successfully.By the agrobacterium-mediated method,the recombination clone 1301TALEN-032296 was transformed into the receptor rice variety TP309.17 transgenic rice plants were obtained.After PCR detection of hygromycin resistance gene and Fok I gene,they were found to be positive transgenic plants carrying 1301TALEN-032296.This research laid some basis for subsequent cold resistant phenotype identification.
Key words:Comparative transcriptome;Dongxiang wild rice;TALEN genome-editing technique
收稿日期:2016-04-20
基金项目:国家自然科学基金项目(31660379);江西省教育厅科学技术研究项目 (GJJ151039)
中图分类号:Q78;S513.08
文献标识码:A
文章编号:1000-7091(2017)03-0013-08
doi:10.7668/hbnxb.2017.03.003